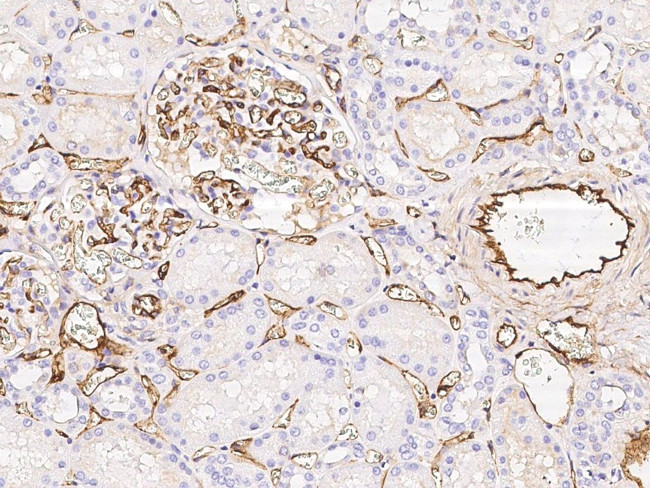
EPCR Antibody in Immunohistochemistry (Paraffin) (IHC (P))

Search
Invitrogen
EPCR Recombinant Rabbit Monoclonal Antibody (041)
{{$productOrderCtrl.translations['antibody.pdp.commerceCard.promotion.promotions']}}
{{$productOrderCtrl.translations['antibody.pdp.commerceCard.promotion.viewpromo']}}
{{$productOrderCtrl.translations['antibody.pdp.commerceCard.promotion.promocode']}}: {{promo.promoCode}} {{promo.promoTitle}} {{promo.promoDescription}}. {{$productOrderCtrl.translations['antibody.pdp.commerceCard.promotion.learnmore']}}




Please note: We are reviewing Western blot images included in the antibody testing data in our catalog, including those provided by third parties. Unless expressly labeled or annotated as “raw-unedited”, Western blot images included in the antibody testing data in our catalog may have been edited, optimized or otherwise adjusted for presentation.
产品信息
MA5-29505
种属反应
宿主/亚型
Expression System
分类
类型
克隆号
抗原
偶联物
形式
浓度
规格
纯化类型
保存液
内含物
保存条件
运输条件
RRID
产品详细信息
This product is preservative free. It is recommended to add sodium azide to avoid contamination (final concentration 0.05%-0.1%).
Recombinant rabbit monoclonal antibodies are produced using in vitro expression systems. The expression systems are developed by cloning in the specific antibody DNA sequences from immunoreactive rabbits. Then, individual clones are screened to select the best candidates for production. The advantages of using recombinant rabbit monoclonal antibodies include: better specificity and sensitivity, lot-to-lot consistency, animal origin-free formulations, and broader immunoreactivity to diverse targets due to larger rabbit immune repertoire.
This antibody has specificity for Human Epcr/PROCR.
靶标信息
The protein encoded by this gene is a receptor for activated protein C, a serine protease activated by and involved in the blood coagulation pathway. The encoded protein is an N-glycosylated type I membrane protein that enhances the activation of protein C. Mutations in this gene have been associated with venous thromboembolism and myocardial infarction, as well as with late fetal loss during pregnancy.
仅用于科研。不用于诊断过程。未经明确授权不得转售。
生物信息学
蛋白别名: Activated protein C receptor; APC receptor; bA42O4.2; CD201; Endothelial cell protein C receptor; Endothelial protein C receptor
基因别名: EPCR; PROCR
Entrez Gene ID: (Human) 10544